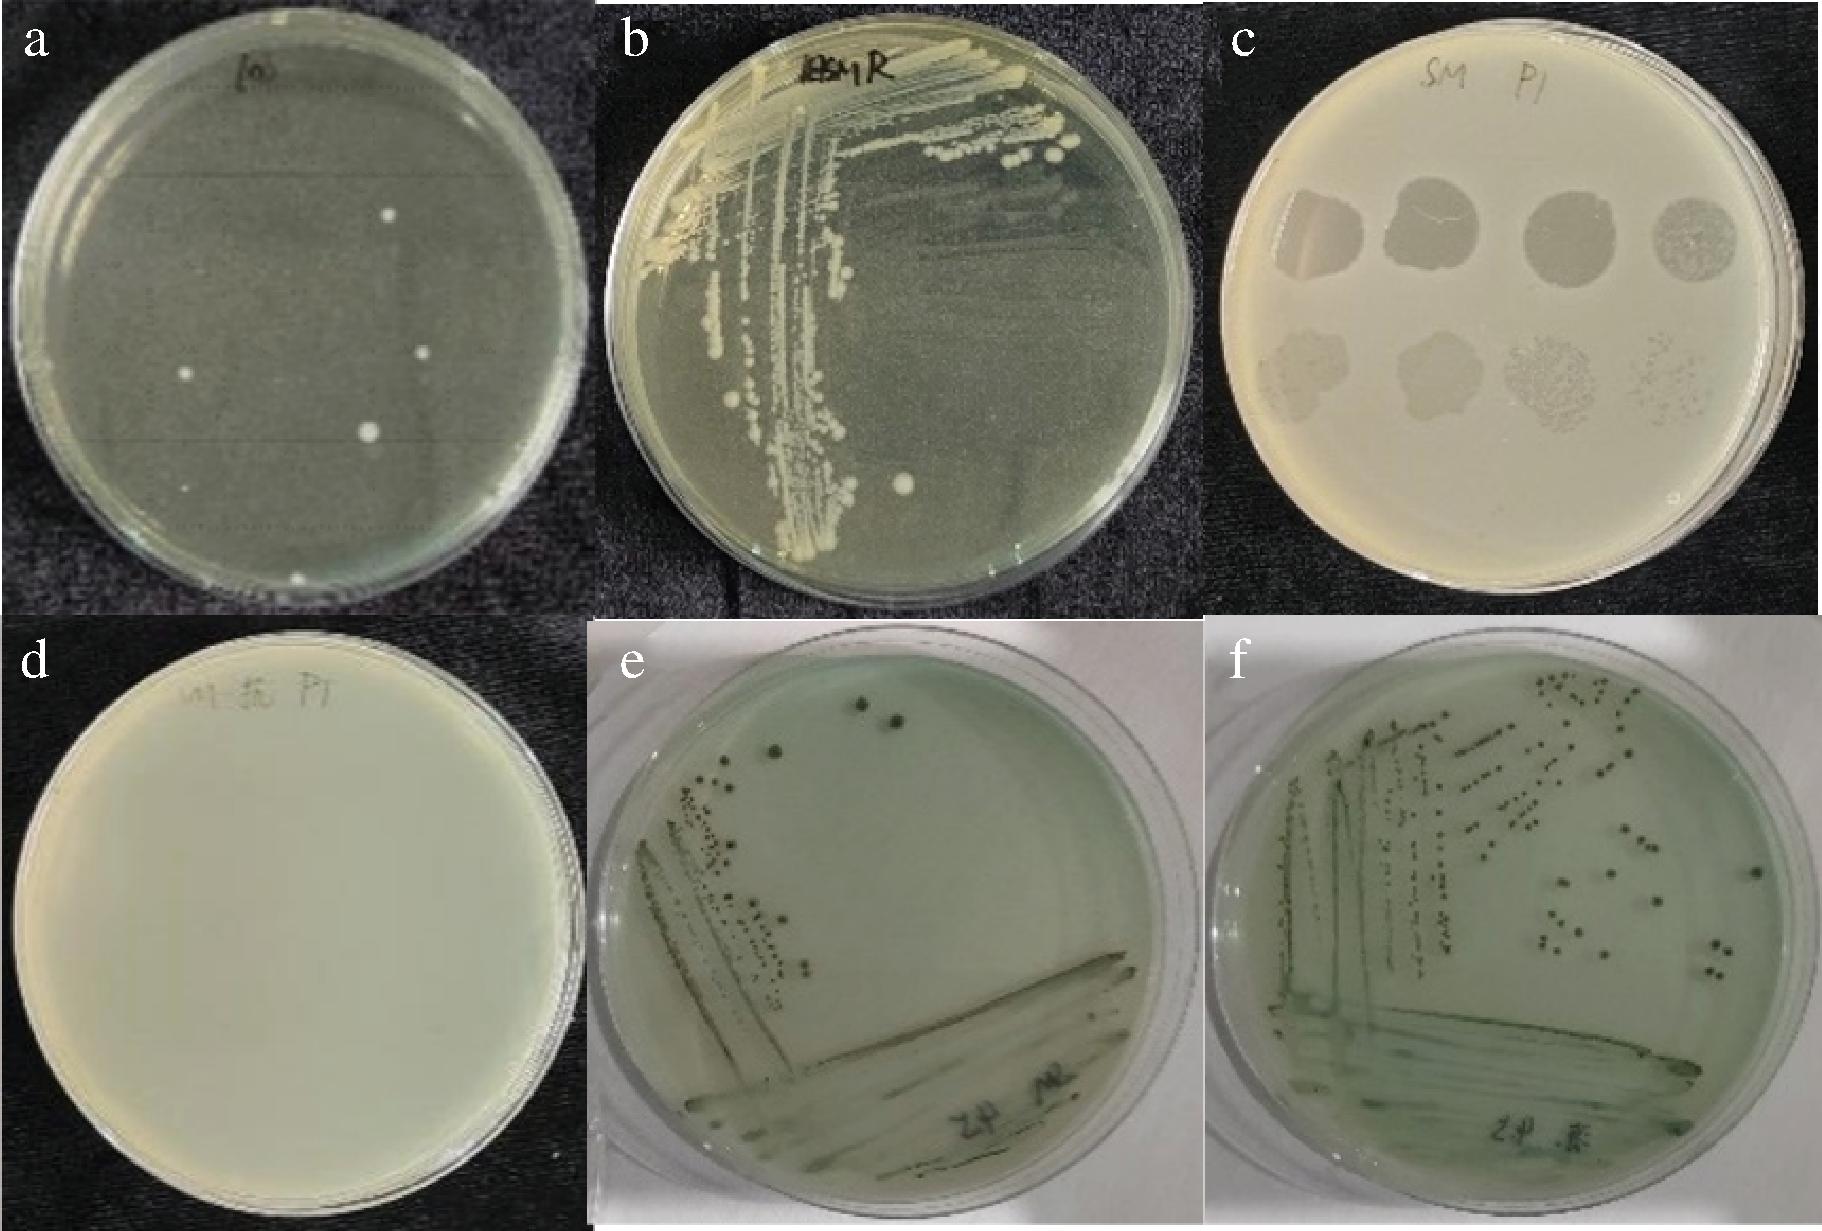
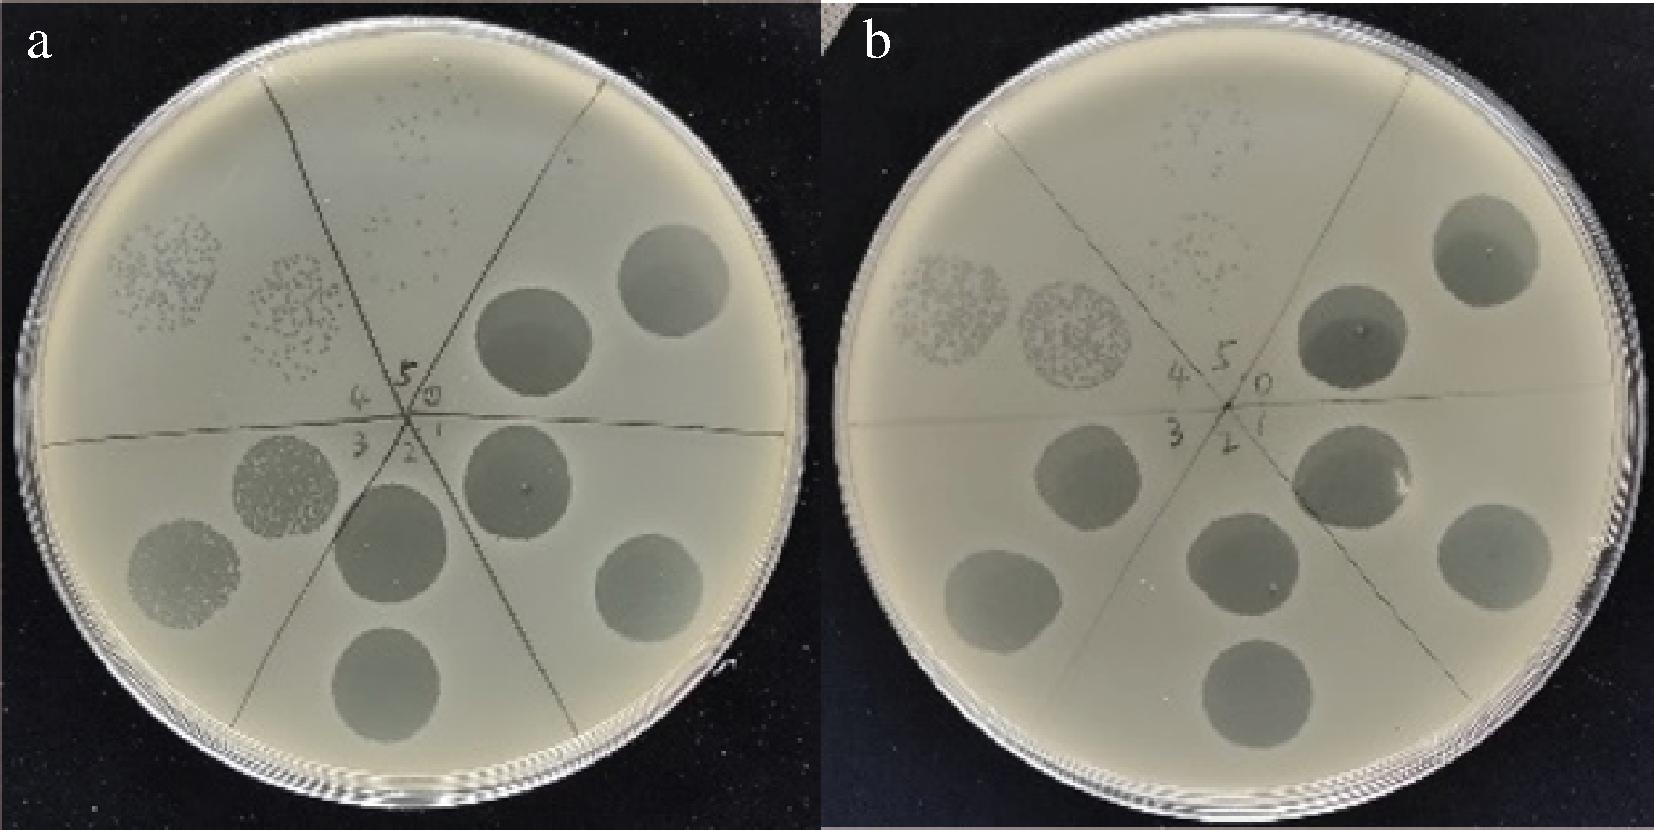

沙门氏菌(Salmonella)是一种革兰氏阴性菌[1-3],是引起人类和动物患食源性疾病的重要致病菌之一[4]。沙门氏菌可以通过食物或水源感染人体[2,5],引起腹泻、腹痛、恶心和呕吐等食物中毒症状[6]。尽管从农场到餐桌各个环节对沙门氏菌的污染都进行一定的预防和控制,但沙门氏菌污染仍然是持续存在的问题[7]。家禽养殖场广泛使用抗生素防治沙门氏菌[8-9],但由于抗生素肆意使用[10]以及抗生素耐药性基因的水平转移[11],导致沙门氏菌的多重耐药性问题日趋严重[12]。
噬菌体疗法即用烈性噬菌体对抗病原菌,是一种有前景的治疗病原菌污染的策略[13]。噬菌体是感染细菌的病毒[14]。与常规抗生素相比,噬菌体具有特异性、对正常菌群无害、发育周期短、成本低、易于使用和贮存[15]。已有研究表明,噬菌体组合可以提高噬菌体的治疗效果[15];ONG等[16]研究使用噬菌体鸡尾酒和抗生素联合使用,研究交叉耐药性来评估它们作为鸡尾酒的潜力。LI等[17]分离出噬菌体phiZ98靶向脂多糖的缺陷株,证实了噬菌体phiZ98可以与靶向脂多糖的假单胞菌株噬菌体联合抑菌。ABHISINGHA等[18]使用2种对沙门氏菌具有高裂解活性的噬菌体混合来抑制冷藏期间鸡肉上沙门氏菌的生长。噬菌体制剂的研究正在快速发展,其安全性和有效性也逐渐得到关注。噬菌体疗法不仅可以扩大裂解范围,还可以减少抗生素使用[19],GAO等[20]研究选择不同受体的4种噬菌体组成噬菌体混合物,证明与单一噬菌体相比,4种混合物可以延迟噬菌体抗性突变体的出现。
地球上约有1031个噬菌体[2,21],它广泛存在于各种环境中,有细菌的地方就有噬菌体存在[2]。宿主菌在被噬菌体裂解时会对噬菌体产生抗性突变,这种现象阻碍了噬菌体制剂的发展和应用[22-23]。研究表明,细菌可以通过阻断噬菌体吸附、阻止噬菌体DNA进入、切割噬菌体基因组、流产感染系统、细菌群体感应等多种机制来对抗噬菌体感染[24-25];同时噬菌体也进化出相应的策略来应对细菌的逃逸机制。噬菌体编码的降解酶可以降解细菌表面受体,促进噬菌体吸附等[26],噬菌体DNA利用宿主的Mtase对自身进行甲基化修饰、逃避切割等,但是这些策略只能暂时躲避宿主的防御[24]。因此,在噬菌体种类众多的情况下,需要正确挑选和配制噬菌体制剂对抗细菌感染[27]。
本研究以噬菌体ZBSTP1及其宿主菌为研究对象,分离噬菌体ZBSTP1抗性菌,通过该抗性菌筛选烈性噬菌体,根据该方法将选出的噬菌体与ZBSTP1进行组合,测定不同噬菌体组合条件下对沙门氏菌的抑制能力,并将其应用在鸡肉中。本研究提供了一种新的挑选噬菌体组合的方法,旨在为对抗沙门氏菌及其他病原菌提供一种安全、有效的解决方案,为噬菌体制剂的开发和应用奠定理论基础。
1 材料与方法
1.1 实验材料
1.1.1 菌株与噬菌体
沙门氏菌(CGMCC 1.0090),于中国科学院微生物研究所(北京)。抗性菌(沙门氏菌对噬菌体ZBSTP1具有抗性的抗性菌)由本研究分离并保存。沙门氏菌噬菌体ZBSTP1、ZBSTP2、ZBSTP3、ZBSTP4、ZBSTP5、ZBSTP6、ZBSTP7、ZBSTP8、ZBSTP9、EC-p9-1、ZCFSTP4、ZCFVPP3均由本实验室自北碚区嘉陵江流域、食品工厂污水处理间分离并保存(分离方法参考解天慧[28]的研究),其中本研究应用于食品中的噬菌体ZBSTP1、EC-p9-1、ZCFSTP4经全基因组测序分析,证明这些噬菌体不含有毒力因子和抗生素耐药基因相关因子,表明其具有较高的生物安全性,具有在食品领域中应用的潜力。
1.1.2 实验试剂
LB培养基、胰酪胨大豆琼脂(tryptose soya agar,TSA)培养基、亚硫酸铋(bismuth sulfite,BS)琼脂培养基,青岛高科技工业园海博生物技术有限公司;琼脂,上海源叶生物科技有限公司;二甲基亚砜,上海生工生物工程有限公司;NaCl(分析纯),上海泰坦科技股份有限公司;盐酸,重庆川东化工有限公司;MgSO4·7H2O(分析纯),成都市科龙化工试剂厂;Tris(分析纯),索莱宝生物技术有限公司;SM缓冲液(2.32 g NaCl、0.8 g MgSO4·7H2O加水溶解,再加入20 mL Tris-HCl、2 mL明胶,定容至400 mL);GelStain核酸染料、全式金DNA提取试剂盒,北京全式金生物技术有限公司。
1.2 仪器与设备
SQP电子天平,德国赛多利斯公司;DHP-9272恒温培养箱,上海沪西分析仪器有限公司;BHC-1300IIA/B3生物安全柜,苏州净化设备有限公司;LDZF-30KB立式压力蒸汽灭菌锅,上海申安医疗器械有限公司;10~1 000 μL移液枪,上海泰坦科技股份有限公司。
1.3 实验方法
1.3.1 抗性菌分离及鉴定
首先增殖噬菌体ZBSTP1,取沙门氏菌菌液4 mL,加入15 mL LB培养基,从-80 ℃冰箱取出已保存的噬菌体ZBSTP1,加入1 mL SM缓冲液中,混匀后加入装有宿主菌液和培养基的锥形瓶中,37 ℃、120 r/min培养16 h。将培养液离心后收集上清液,上清液用0.22 μm滤膜过滤除菌,得到噬菌体原液。
取500 μL噬菌体原液和等体积过夜培养的沙门氏菌混合,孵育15 min。然后向混合物中加入4.5 mL LB软琼脂混匀,倒双层板,于37 ℃静置培养24 h,待平板上长出菌落后,挑取单菌落在含有噬菌体ZBSTP1的平板上划线,重复3~5次,直至获得大小、形态相同的菌落,取单菌落于20 mL LB培养基中,37 ℃、120 r/min培养16 h,制成细菌悬液。取500 μL菌悬液倒双层板,取10 μL噬菌体ZBSTP1的稀释液点在双层板上,待其干燥后于37 ℃培养16 h,若噬菌体不能裂解该菌,则说明得到了对噬菌体ZBSTP1具有稳定抗性的抗性菌,并命名为SMR。
取单菌落在沙门氏菌选择BS琼脂培养基上划线,观察是否具有典型沙门氏菌菌落特征,为进一步排除杂菌污染,利用全式金DNA提取试剂盒对沙门氏菌和抗性菌SMR的DNA进行提取,用16S rRNA通用引物进行扩增,其中,正向引物为27 F(5′-AGAGTTTGATCMTGGCTCAG-3′),反向引物为1492 R(5′-GGTTACCTTGTTACGACTT-3′)。扩增程序为95 ℃预变性5 min,95 ℃变性30 s,53 ℃退火30 s,72 ℃延伸1 min,72 ℃终延伸5 min,30个循环,4 ℃保存,PCR体系(表1)。PCR产物由上海生物工程公司进行测序,测序结果在NCBI网站、BLAST数据库中进行比对。
表1 PCR试剂及用量
Table 1 PCR reagents and dosage

组成用量/μL模板DNA1Taq酶0.510×Easy Taq Buffer(+Mg2+)3dNTP Mix2.4引物F0.6引物R0.6ddH2O21.9体系30
最终将纯化好的菌接种到TSA平板上,过夜培养后,挑取单个菌落接种到LB培养基,37 ℃培养16 h后,取培养液,加入10%(体积分数)二甲亚砜溶液混合均匀后于-80 ℃保藏。
1.3.2 SMR烈性噬菌体筛选
增殖噬菌体ZCFSTP4、EC-p9-1、ZCFVPP3、ZBSTP2、ZBSTP3、ZBSTP4、ZBSTP5、ZBSTP6、ZBSTP7、ZBSTP8、ZBSTP9;将增殖液离心后,用0.22 μm滤膜过滤,得到增殖后的噬菌体原液备用。
挑取SMR的单菌落于20 mL LB培养基中,摇床培养16 h,制成菌悬液。倒SMR的双层平板,分别用增殖后的噬菌体原液进行点板,于37 ℃培养16 h,观察有无噬菌斑。取过夜培养的沙门氏菌和SMR菌液,采用双层平板法进一步测定噬菌体的成斑效率(efficiency of plaquing,EOP)值[29],记录噬菌斑数量,成斑效率计算如公式(1)所示。EOP≥0.5表明对该细菌具有高裂解能力(++++),0.1≤EOP<0.5表明裂解效果中等(+++),0.001≤EOP<0.1表明裂解效果低(++),EOP <0.001(-)表明噬菌体不能裂解该细菌。选择出最终能裂解抗性菌的噬菌体进行后续实验。
成斑效率![]()
(1)
1.3.3 SMR烈性噬菌体受体结合蛋白分析及三级结构对比
对噬菌体ZBSTP1、SMR烈性噬菌体进行全基因组测序,使用RAST(Rapid Annotation using Subsystem Technology)网站[RAST Server-RAST Annotation Server (nmpdr.org)]对基因组开放阅读框编码的蛋白序列进行功能注释[30],找到受体结合蛋白(receptor binding protein,RBP)的编码基因,使用DNAMAN软件分别比对噬菌体ZBSTP1与SMR烈性噬菌体之间RBP的氨基酸相似性;通过SWISS-MODEL在线网站[SWISS-MODEL (expasy.org)][31]分别对噬菌体ZBSTP1与SMR烈性噬菌体之间的RBP进行三级结构预测比对。
1.3.4 最佳感染复数测定
噬菌体感染复数(multiple of infection,MOI)是指在特定时间可以吸附的噬菌体数量与宿主菌数量的比值,是噬菌体侵染能力的重要指标[32]。将噬菌体与对数期的沙门氏菌按照0.001、0.01、0.1、1、10的感染复数比例混合,取200 μL加到LB培养基中,于37 ℃培养3 h,14 700 r/min离心3 min,利用双层平板法测定噬菌体效价,噬菌体效价最高的比例为最佳感染复数。
1.3.5 抑菌曲线测定
为了研究噬菌体对沙门氏菌的抑制效果,进行了噬菌体与沙门氏菌共培养实验,具体方法如下:沙门氏菌过夜培养后,取400 μL加入39.6 mL LB培养基中,于37 ℃、120 r/min条件下培养至OD600≈0.5。在单噬菌体实验中,噬菌体加入量为1 mL(体积分数约2.5%,基于40 mL总体积);双噬菌体混合时,加入噬菌体体积为0.5 mL+0.5 mL(每种噬菌体体积分数约1.25%,基于40 mL);三噬菌体混合时,加入噬菌体体积分别为0.33 mL+0.33 mL+0.33 mL(每种噬菌体体积分数约0.82%,基于40 mL)。所有组合均在37 ℃、120 r/min下培养12 h,测定OD600值。分别选择双噬菌体和三噬菌体组合进行混合比例的优化,以进一步延长抑菌时间。
1.3.6 噬菌体组合在鸡肉中的应用
将生鸡胸肉切成1.5 cm×1.5 cm薄片(每片质量约1.2 g),表面通过喷洒75%体积分数酒精进行消毒,然后在超净工作台紫外照射至少30 min[16]。取100 μL沙门氏菌(106 CFU/mL)接种在鸡胸肉上,孵育30 min。然后将选定的噬菌体组合进行配制,取该组合噬菌体100 μL喷洒在鸡胸肉上。分别在4 ℃和25 ℃条件下存放,在不同时间点收集样品(0、1、2、3、4、5、6、7、8、9、10、11、12、24、48 h),立即测定沙门氏菌菌落数,对照组采用SM缓冲液代替噬菌体组合进行处理。测定菌落数的平板采用沙门氏菌选择培养基。
2 结果与分析
2.1 抗性菌分离及鉴定
将噬菌体ZBSTP1与宿主菌混合,倒双层平板培养24 h后,平板上出现几个单菌落,这几个单菌落为分离出来的对噬菌体ZBSTP1具有抗性的抗性菌(图1-a),从该平板上挑取单菌落在含有噬菌体ZBSTP1的平板上划线,纯化4次,得到形态均一、稳定的单菌落(图1-b)。噬菌体ZBSTP1在含有沙门氏菌宿主的双层平板上,有清晰透明的噬菌斑(图1-c),在含有抗性菌的双层平板上,没有出现噬菌斑(图1-d),说明噬菌体ZBSTP1不能将其裂解,因此分离出了对噬菌体ZBSTP1具有稳定抗性的抗性菌。为了排除杂菌污染,用沙门氏菌选择培养基进行验证,沙门氏菌在BS琼脂平板上菌落颜色呈黑色,有金属光泽,具有典型的沙门氏菌菌落特征(图1-e),分离的抗性菌具有相同的典型沙门氏菌菌落特征(图1-f)。特异性扩增沙门氏菌和抗性菌的16S rRNA序列,凝胶电泳检测产物条带大小正确(图2-a),测序比对结果显示该抗性菌仍为沙门氏菌(图2-b)。
a-抗性菌分离;b-抗性菌纯化;c-ZBSTP1裂解沙门氏菌;d-ZBSTP1不裂解抗性菌;e-沙门氏菌菌落形态;f-抗性菌菌落形态
图1 抗性菌分离鉴定
Fig.1 Isolation and identification of resistant bacteria

M:5 000 bp Marker;1:沙门氏菌;2:抗性菌。a-凝胶电泳检测16S rRNA图;b-抗性菌测序结果比对
图2 抗性菌的16S rRNA鉴定
Fig.2 16S rRNA identification of resistant bacteria sequencing results
2.2 SMR烈性噬菌体筛选
噬菌体EC-p9-1的EOP值>0.5,表明该噬菌体对SMR具有高裂解能力;噬菌体ZCFSTP4的EOP值在0.1~0.5之间,表明该噬菌体对SMR具有中等裂解能力;噬菌体ZCFVPP3、ZBSTP9、ZBSTP8、ZBSTP7、ZBSTP6、ZBSTP5、ZBSTP4、ZBSTP3、ZBSTP2在抗性菌的双层板上没有产生噬菌斑,其EOP值小于0.001,表明噬菌体不能裂解SMR(表2)。
表2 噬菌体对SMR的EOP
Table2 Spotting EOP on SMR

细菌菌株噬菌体EOP裂解能力SMREC-p9-1>0.5++++ZCFSTP40.1^0.5+++ZCFVPP3<0.001-ZBSTP9<0.001-ZBSTP8<0.001-ZBSTP7<0.001-ZBSTP6<0.001-ZBSTP5<0.001-ZBSTP4<0.001-ZBSTP3<0.001-ZBSTP2<0.001-
注:++++表示EOP≥0.5;+++表示0.1≤EOP<0.5;++表示0.001≤EOP<0.1;-表示EOP<0.001,噬菌体不能裂解该细菌。
噬菌体EC-p9-1在 SMR的双层板上,有清晰的噬菌斑产生,表明该噬菌体可以裂解SMR(图3-a);噬菌体ZCFSTP4有噬菌斑产生,表明该噬菌体可以裂解SMR(图3-b)。因此选择噬菌体EC-p9-1和ZCFSTP4做后续实验。
a-EC-p9-1裂解SMR;b-ZCFSTP4裂解SMR
图3 EC-p9-1、ZCFSTP4对SMR的噬斑实验
Fig.3 Spot test of EC-p9-1 and ZCFSTP4 on SMR
2.3 噬菌体RBP及三级结构预测分析
RBP可以与宿主细胞表面的脂多糖、外膜蛋白、鞭毛等特定位点相互作用,帮助噬菌体进行宿主识别、吸附和基因组释放。作为噬菌体与宿主接触的第一个作用位点,噬菌体的RBP是决定其宿主范围的关键因素之一。
分析噬菌体ZBSTP1和EC-p9-1以及与ZCFSTP4的RBP的相似性,研究噬菌体ZBSTP1、EC-p9-1、ZCFSTP4可以共同裂解沙门氏菌的原因,结果显示:三者RBP相似性为98.03%,表明它们可能对沙门氏菌具有相同的吸附位点,因此三者都可以裂解沙门氏菌(图4-a);其中噬菌体ZBSTP1与EC-p9-1的RBP相似性为96.63%(图4-b),噬菌体ZBSTP1与ZCFSTP4的RBP相似性为96.12%(图4-c);表明噬菌体ZBSTP1与EC-p9-1的RBP之间存在3.37%的差异,表现差异的氨基酸有:天门冬氨酸、谷氨酰胺、甘氨酸、亮氨酸、丝氨酸、苏氨酸、丙氨酸、酪氨酸、缬氨酸、异亮氨酸;噬菌体ZBSTP1与ZCFSTP4的RBP之间存在3.88%的差异,表现差异的氨基酸有:谷氨酰胺、甘氨酸、亮氨酸、天门冬酰胺、丝氨酸、丙氨酸、酪氨酸、缬氨酸、谷氨酸、异亮氨酸。将噬菌体ZBSTP1与ZCFSTP4;ZBSTP1与EC-p9-1的三级结构进行对比,噬菌体EC-p9-1的三级结构标记为黄色,噬菌体ZBSTP1标记为蓝色,三级结构比对见图5-a,噬菌体ZBSTP1的RBP三级结构标记为蓝色,ZCFSTP4标记为黄色,三级结构比对见图5-b,通过三级结构对比,可以看出,氨基酸的不同导致噬菌体ZBSTP1与ZCFSTP4和EC-p9-1也存在结构差异。以上差异可能是导致EC-p9-1、ZCFSTP4可以裂解抗性菌的原因。

a-ZBSTP1与EC-p9-1、ZCFSTP4;b-ZBSTP1与EC-p9-1;c-ZBSTP1与ZCFSTP4
图4 ZBSTP1、EC-p9-1、ZCFSTP4的RBP氨基酸比对分析
Fig.4 ZBSTP1, EC-p9-1, ZCFSTP4 RBP amino acid alignment analysis

a-ZBSTP1与EC-p9-1;b-ZBSTP1与ZCFSTP4
图5 噬菌体RBP三级结构对比
Fig.5 RBP amino acid alignment analysis
2.4 最佳感染复数测定
不同噬菌体对同一种细菌的最佳感染复数可能会因为噬菌体对细菌的裂解能力不同而有差异,分别测定了噬菌体ZBSTP1、EC-p9-1和ZCFSTP4对沙门氏菌的感染复数,结果显示噬菌体ZBSTP1和EC-p9-1在MOI=0.001时获得最高效价,因此噬菌体ZBSTP1和EC-p9-1的最佳感染复数为0.001;噬菌体ZCFSTP4在MOI=10时获得最高效价,因此噬菌体ZCFSTP4的最佳感染复数为10(表3)。
表3 噬菌体最佳感染复数 单位:PFU/mL
Table3 MOI of phages

噬菌体感染复数1010.10.010.001ZBSTP14.8×1088.25×1061.9×1086.1×1081.11×109EC-p9-12.45×1043.6×1063×1081.18×1092.3×109ZCFSTP42.88×1097.9×1076.24×1073.55×1061.2×108
2.5 不同噬菌体组合抑制沙门氏菌生长曲线测定
为了评估噬菌体对沙门氏菌生长的抑制效果,比较了单个噬菌体和噬菌体鸡尾酒的抑制效果。结果显示:噬菌体ZBSTP1按照体积分数2.50%(下同)加入到沙门氏菌培养液中后,2 h起快速抑菌至6 h,此后,耐噬菌体菌株出现,菌液OD600值缓慢增加。噬菌体EC-p9-1(2.50%)加入后可缓慢抑菌10 h,此后,耐噬菌体菌株缓慢生长。噬菌体ZCFSTP4(2.50%)自加入后便开始快速抑菌6 h,之后有耐噬菌体菌株出现,导致菌液OD600值缓慢增加,在抑菌阶段,ZCFSTP4表现较好(图6-a)。

a-单噬菌体;b-噬菌体组合;c-不同噬菌体组合优化后
图6 噬菌体组合对沙门氏菌抑菌时间
Fig.6 Bacteriostatic time of different phage combinations against Salmonella
双噬菌体组合ZBSTP1与EC-p9-1及ZBSTP1与ZCFSTP4,每种组合中噬菌体按照1.25%加入,用于抑制沙门氏菌生长。前者加入后1 h抑菌效果增加,在12 h内可以有效抑制沙门氏菌生长且没有耐噬菌体菌株产生;后者自加入后即展现抑菌效果,持续时间8 h。三噬菌体组合ZBSTP1、EC-p9-1和ZCFSTP4,每种噬菌体按照0.82%加入,自加入后开始抑菌,持续时间为8 h,之后有耐噬菌体菌株产生。尽管ZBSTP1+ZCFSTP4组合与ZBSTP1+ EC-p9-1+ZCFSTP4组合抑菌时间较短,但是在抑菌阶段抑菌效果较好(图6-b)。虽然三噬菌体组合中噬菌体种类增加,但抑菌效果相较于双噬菌体组合并未明显增加,其原因可能是噬菌体之间存在某种竞争抑制,一种噬菌体感染细菌后会干扰其他具有共同宿主噬菌体正确组装和繁殖的能力[33],从而影响了噬菌体组合的抑菌效果。
为了延长抑菌时间,分别按照以下体积分数加入了噬菌体ZBSTP1和ZCFSTP4至沙门氏菌培养液中:ZBSTP1 2.50%(1 mL/40 mL),ZCFSTP4 5.00%(2 mL/40 mL);ZBSTP1 5.00%(2 mL/40 mL),ZCFSTP4 2.50%(1 mL/40 mL);ZBSTP1与ZCFSTP4均为3.75%(1.5 mL/40 mL),这些组合在12 h内均有效抑制了沙门氏菌生长,且未观察到耐噬菌体菌株产生,噬菌体ZBSTP1与ZCFSTP4均为2.50%(1 mL/40 mL),抑菌时间持续9 h,但后期有耐噬菌体菌株产生,根据抑菌曲线分析,最终选择噬菌体ZBSTP1体积分数5.00%,ZCFSTP4体积分数2.50%的组合进行应用。对于ZBSTP1和EC-p9-1的组合,按照加入噬菌体均为2.50%(体积分数)混合,加入后2 h开始快速抑菌,抑菌时间持续至12 h且后期没有耐噬菌体菌株产生,与加入体积分数1.25%相比,后者抑菌作用发挥时间较早,因此选择噬菌体ZBSTP1+ EC-p9-1体积分数均为1.25%进行应用。对于噬菌体ZBSTP1+EC-p9-1+ZCFSTP4的组合,按照加入噬菌体体积分数均为2.50%,抑菌时间持续9 h,后期有耐噬菌体菌株产生,但是比加入噬菌体体积分数为0.82%的组合抑菌效果好(图6-c)。
实验结果显示,无论是单一噬菌体、双噬菌体组合还是三噬菌体组合,均对沙门氏菌的生长展现出显著的抑制效果。最终选择双噬菌体组合ZBSTP1、EC-p9-1(1.25%);ZBSTP1(5.00%),ZCFSTP4(2.50%);ZBSTP1、EC-p9-1、ZCFSTP4(2.50%)在鸡肉中进行应用,以评估其实际的抑菌效果。
2.6 噬菌体组合在鸡肉中的抑菌作用
为了探究噬菌体鸡尾酒在食品中的实际效用,本研究选取鸡肉作为实验对象,针对沙门氏菌进行抑菌效果评估。在4 ℃条件下,对照组鸡肉中的沙门氏菌呈现出缓慢生长的趋势。相比之下,实验组在加入噬菌体ZBSTP1和ZCFSTP4组合后,沙门氏菌的生长受到显著抑制,在24 h内该组合可以有效抑制鸡肉中沙门氏菌生长,与对照组相比,菌落数下降1.90 lg CFU/mL(图7-a)。在25 ℃贮存条件下,对照组的沙门氏菌随着时间推移呈现增长态势。但是,在实验组中,添加噬菌体ZBSTP1和ZCFSTP4组合后,沙门氏菌生长受到明显抑制,从加入后1 h开始,沙门氏菌菌落数开始下降,且在12 h内有效地控制了鸡肉中沙门氏菌的增殖。与对照组相比,噬菌体组合处理组的菌落数下降2.92 lg CFU/mL(图7-b),显示出良好的抑菌效果。在4 ℃条件下,噬菌体的抑菌作用持续时间较25 ℃条件下延长了12 h。这可能是由于低温条件与噬菌体的协同作用共同增强了抑菌效果。随着抑菌时间的进一步延长,菌落数开始回升,这可能是出现了新的耐噬菌体菌株。

a-ZBSTP1和ZCFSTP4,4 ℃贮存;b-ZBSTP1和ZCFSTP4,25 ℃贮存;c-ZBSTP1和EC-p9-1,4 ℃贮存;d-ZBSTP1和EC-p9-1,25 ℃贮存;e-ZBSTP1,EC-p9-1和ZCFSTP4,4 ℃贮存;f-ZBSTP1, EC-p9-1和ZCFSTP4,25 ℃贮存
图7 噬菌体组合在鸡肉上抑制沙门氏菌的效果
Fig.7 Efficiency of the phage combination on reduction of Salmonella contamination on chicken
噬菌体ZBSTP1与EC-p9-1联合应用在4 ℃的低温条件下,在加入后1 h内,噬菌体组合迅速发挥作用,显著降低鸡肉中沙门氏菌数量,并可以在12 h内有效抑制鸡肉中沙门氏菌的增殖(图7-c);同样地,在25 ℃的环境中,该组合亦能在12 h内显著抑制鸡肉中沙门氏菌的生长(图7-d)。
在4 ℃环境下,噬菌体ZBSTP1、EC-p9-1与ZCFSTP4的联合应用展现出了对鸡肉中沙门氏菌生长的显著抑制效果。前期无论是对照组还是噬菌体处理组,沙门氏菌生长均较为缓慢,这可能是因为低温环境本身对沙门氏菌增殖起到抑制作用,以及噬菌体组合协同抑菌的结果。随着实验时间的延长,对照组沙门氏菌数量逐渐增加,说明低温环境虽然能减缓细菌生长但是不能完全阻止。相比之下,噬菌体处理组中沙门氏菌数量并未明显增加,表明该噬菌体组合能够在48 h内有效遏制鸡肉中沙门氏菌的生长(图7-e)。在25 ℃环境中,该噬菌体组合同样展现出了对沙门氏菌生长的显著抑制效果。与对照组相比,处理组中的沙门氏菌生长速度明显放缓。特别是在前12 h内,噬菌体组合迅速发挥作用,显著降低了沙门氏菌的数量。此外,这种抑制效果在实验进行到48 h时依然持续存在,进一步证实了该噬菌体组合在不同温度下对沙门氏菌生长的长期抑制能力(图7-f)。因此,噬菌体ZBSTP1、EC-p9-1与ZCFSPT4的联合应用在不同温度条件下均能有效抑制鸡肉中沙门氏菌的生长。
综上,实际应用中可以考虑采用间隔添加噬菌体的策略,以达到更为持久和有效的抑菌效果,在未来研究中可以进一步探索噬菌体与食品级的抗菌剂联合应用,提高抑菌效果并减少抗性菌株的产生,为食品安全和食品保鲜提供了新的解决方案。
3 结论
本研究筛选分离了ZBSTP1的抗性菌,选择出抗性菌烈性噬菌体EC-p9-1和ZCFSTP4,探讨了3种噬菌体单独及组合使用时在不同加入量下对沙门氏菌生长的抑制效果,并将其应用在鸡肉样品中。结果表明,双噬菌体组合ZBSTP1+ZCFSTP4在4 ℃和25 ℃条件下对沙门氏菌的抑制作用分别持续24 h和12 h;另一双噬菌体组合ZBSTP1+EC-p9-1抑菌效果持续12 h;而三噬菌体组合ZBSTP1+EC-p9-1+ZCFSTP4则可以在48 h内持续抑制沙门氏菌的生长。此外,通过实验发现,由于噬菌体之间存在竞争,在选择噬菌体进行组合时,并不是噬菌体种类、加入量越多越好,因此,选择加入正确及适量的噬菌体对组合噬菌体抑菌至关重要,该研究为今后噬菌体鸡尾酒配制提供了一种新的方式,有助于相关噬菌体制剂的开发和应用。
[1] BAO H D, ZHANG P Y, ZHANG H, et al.Bio-control of Salmonella enteritidis in foods using bacteriophages[J].Viruses, 2015, 7(8):4836-4853.
[2] 孙新城, 许素月, 李侠颖, 等.基于噬菌体的食源性致病菌检测方法研究进展[J].食品与发酵工业, 2023, 49(9):340-347.SUN X C, XU S Y, LI X Y, et al.Advances in bacteriophage-based detection of foodborne pathogens[J].Food and Fermentation Industries, 2023, 49(9):340-347.
[3] 丛瑜, 林洪, 王静雪.多价噬菌体内溶素的阳离子肽修饰及抗菌效果[J].食品与发酵工业, 2022, 48(20):1-6.CONG Y, LIN H, WANG J X.Development of cationic peptide chimeric lysins based on polyvalent phage lysin and their antibacterial activities[J].Food and Fermentation Industries, 2022, 48(20):1-6.
[4] SONG X Y, WANG H H, SHAO X F, et al.Au@Ag core-shell nanorods enhance surface-enhanced Raman scattering aptasensor for ultrasensitive detection of Salmonella Typhimurium[J].Food Control, 2024, 161:110379.
[5] 吴昊, 胡丽颖, 路娟娥.鼠伤寒沙门氏菌的感染及治疗研究进展[J].食品与发酵工业, 2024, 50(16):359-366.WU H, HU L Y, LU J E.Research progress on infection and treatment of Salmonella Typhimurium[J].Food and Fermentation Industries, 2024, 50(16):359-366.
[6] KIM S, CHANG Y.Anti-Salmonella polyvinyl alcohol coating containing a virulent phage PBSE191 and its application on chicken eggshell[J].Food Research International, 2022, 162:111971.
[7] ANJAY, KUMAR A, ABHISHEK, et al.Isolation and characterization of Salmonella phages and phage cocktail mediated biocontrol of Salmonella enterica serovar Typhimurium in chicken meat[J].LWT, 2022, 155:112957.
[8] SHALABY A, ISMAIL M M, EL-SHARKAWY H.Isolation, identification, and genetic characterization of antibiotic resistance of Salmonella species isolated from chicken farms[J].Journal of Tropical Medicine, 2022, 2022(1):6065831.
[9] RUVALCABA-G MEZ J M, VILLAGR
MEZ J M, VILLAGR N Z, VALDEZ-ALARC
N Z, VALDEZ-ALARC N J J, et al.Non-antibiotics strategies to control Salmonella infection in poultry[J].Animals, 2022, 12(1):102.
N J J, et al.Non-antibiotics strategies to control Salmonella infection in poultry[J].Animals, 2022, 12(1):102.
[10] CHAUDHARI R, SINGH K, KODGIRE P.Biochemical and molecular mechanisms of antibiotic resistance in Salmonella spp[J].Research in Microbiology, 2023, 174(1-2):103985.
[11] BAKKEREN E, GÜL E, HUISMAN J S, et al.Impact of horizontal gene transfer on emergence and stability of cooperative virulence in Salmonella Typhimurium[J].Nature Communications, 2022, 13:1939.
[12] 赵泰霞, 周圆圆, 田雯欣, 等.白羽鸡致病性大肠杆菌、沙门氏菌的分离鉴定及抗生素耐受性分析[J].微生物学通报, 2024, 51(7):2563-2575.ZHAO T X, ZHOU Y Y, TIAN W X, et al.Isolation, identification and antibiotic resistance analysis of pathogenic Escherichia coli and Salmonella from white feather broiler[J].Microbiology China, 2024, 51(7):2563-2575.
[13] WANG S, MIRMIRAN S D, LI X M, et al.Temperate phage influence virulence and biofilm-forming of Salmonella Typhimurium and enhance the ability to contaminate food product[J].International Journal of Food Microbiology, 2023, 398:110223.
[14] 相强宇, 马丽丽, 高婉莹, 等.基于专利情报的噬菌体合成生物学发展态势[J].微生物学通报, 2025, 52(4):1840-1860.XIANG Q Y, MA L L, GAO W Y, et al.Development trends of phage synthetic biology based on patent intelligence[J].Microbiology China, 2025, 52(4):1840-1860.
[15] YU H B, ZHANG L, FENG C, et al.A phage cocktail in controlling phage resistance development in multidrug resistant Aeromonas hydrophila with great therapeutic potential[J].Microbial Pathogenesis, 2022, 162:105374.
[16] ONG S P, AZAM A H, SASAHARA T, et al.Characterization of Pseudomonas lytic phages and their application as a cocktail with antibiotics in controlling Pseudomonas aeruginosa[J].Journal of Bioscience and Bioengineering, 2020, 129(6):693-699.
[17] LI D H, LI Y Y, LI P Z, et al.Phage phiZ98:A novel tri-segmented dsRNA cystovirus for controlling Pseudomonas strains with defective lipopolysaccharides in foods[J].Food Research International, 2022, 162:112197.
[18] ABHISINGHA M, DUMNIL J, PITAKSUTHEEPONG C.Efficiency of phage cocktail to reduce Salmonella Typhimurium on chicken meat during low temperature storage[J].LWT, 2020, 129:109580.
[19] 唐路遥. 噬菌体鸡尾酒对肉鸡生长性能的影响[D].武汉:华中农业大学, 2022.TANG L Y.Effect of phage cocktail on growth performance of broilers[D].Wuhan:Huazhong Agricultural University, 2022.
[20] GAO D Y, JI H Y, WANG L K, et al.Fitness trade-offs in phage cocktail-resistant Salmonella enterica serovar enteritidis results in increased antibiotic susceptibility and reduced virulence[J].Microbiology Spectrum, 2022, 10(5):e0291422.
[21] 戚少含, 谭贵良, 陈穗, 等.发酵食品中噬菌体多样性、辅助代谢功能及宿主互作研究进展[J].食品科学, 2024, 45(22):300-310.QI S H, TAN G L, CHEN S, et al.Research progress on phage diversity, auxiliary metabolic functions and host interactions in fermented foods[J].Food Science, 2024, 45(22):300-310.
[22] 蔡若鹏. 噬菌体GH-K3的生物学特性及其诱导肺炎克雷伯菌产生噬菌体抗性的机制[D].长春:吉林大学, 2019.CAI R P.Biological characteristics of phage GH-K3 and the mechanism of inducing phage resistance in Klebsiella pneumoniae[D].Changchun:Jilin University, 2019.
[23] 张德福, 杨雯静, 刘可, 等.副溶血性弧菌噬菌体vB_VpP_1裂解酶的生物信息学分析、原核表达及生物活性鉴定[J].食品科学, 2025, 46(3):83-89.ZHANG D F, YANG W J, LIU K, et al.Bioinformatics analysis, prokaryotic expression and biological activity of lysin from Vibrio parahaemolyticus phage vB_VpP_1[J].Food Science, 2025, 46(3):83-89.
[24] 张明阳, 任彪, 贾燕涛.细菌与噬菌体相互抵抗机制研究进展[J].微生物学通报, 2021, 48(9):3293-3304.ZHANG M Y, REN B, JIA Y T.Research progress on the mutual resistance mechanisms between bacteria and bacteriophages[J].Microbiology China, 2021, 48(9):3293-3304.
[25] 韩生义. 沙门氏菌的噬菌体试验性治疗及噬菌体抗性机制研究[D].兰州:甘肃农业大学, 2020.HAN S Y.The experimental treatment of Samonella phage and study on the mechanism of phage resistnace[D].Lanzhou:Gansu Agricultural University, 2020.
[26] LIU Y N, LEUNG S S Y, HUANG Y, et al.Identification of two depolymerases from phage IME205 and their antivirulent functions on K47 capsule of Klebsiella pneumoniae[J].Frontiers in Microbiology, 2020, 11:218.
[27] 范亚娟. 沙门菌噬菌体鸡尾酒制剂的研制及体外杀菌效果评价[D].南京:南京农业大学, 2020.FAN Y J.Development of Salmonella bacteriophage cocktail preparation and evaluation of its in vitro sterilization effect[D].Nanjing:Nanjing Agricultural University, 2020.
[28] 解天慧. 大肠杆菌O157:H7和沙门氏菌噬菌体及其内溶酶和穿孔素的研究[D].重庆:西南大学, 2021.XIE T H.Studies on phages against E.coli O157:H7 and Salmonella spp.and their endolysin and holin[D].Chongqing:Southwest University, 2021.
[29] 刘半红, 胡梁斌, 陆睿, 等.单核细胞增生李斯特氏菌内化素InlJ对噬菌体敏感性及生物被膜形成的影响[J].食品科学, 2023, 44(16):198-204.LIU B H, HU L B, LU R, et al.Effect of internalin InlJ of Listeria monocytogenes on phage sensitivity and biofilm formation[J].Food Science, 2023, 44(16):198-204.
[30] AZIZ R K, BARTELS D, BEST A A, et al.The RAST Server:Rapid annotations using subsystems technology[J].BMC Genomics, 2008, 9:75.
[31] GUEX N, PEITSCH M C, SCHWEDE T.Automated comparative protein structure modeling with SWISS-MODEL and Swiss-PdbViewer:A historical perspective[J].ELECTROPHORESIS, 2009, 30(S1):S162-S173.
[32] 王越, 林洪, 王静雪.一株空肠弯曲菌噬菌体vB_Cj_QDYZ的生物学特性和全基因组分析[J].食品与发酵工业, 2023, 49(18):9-19.WANG Y, LIN H, WANG J X.Biological characteristics and genome analysis of a lytic phage vB_Cj_QDYZ infecting Campylobacter jejuni[J].Food and Fermentation Industries, 2023, 49(18):9-19.
[33] BIRKHOLZ E A, MORGAN C J, LAUGHLIN T G, et al.An intron endonuclease facilitates interference competition between coinfecting viruses[J].Science, 2024, 385(6704):105-112.